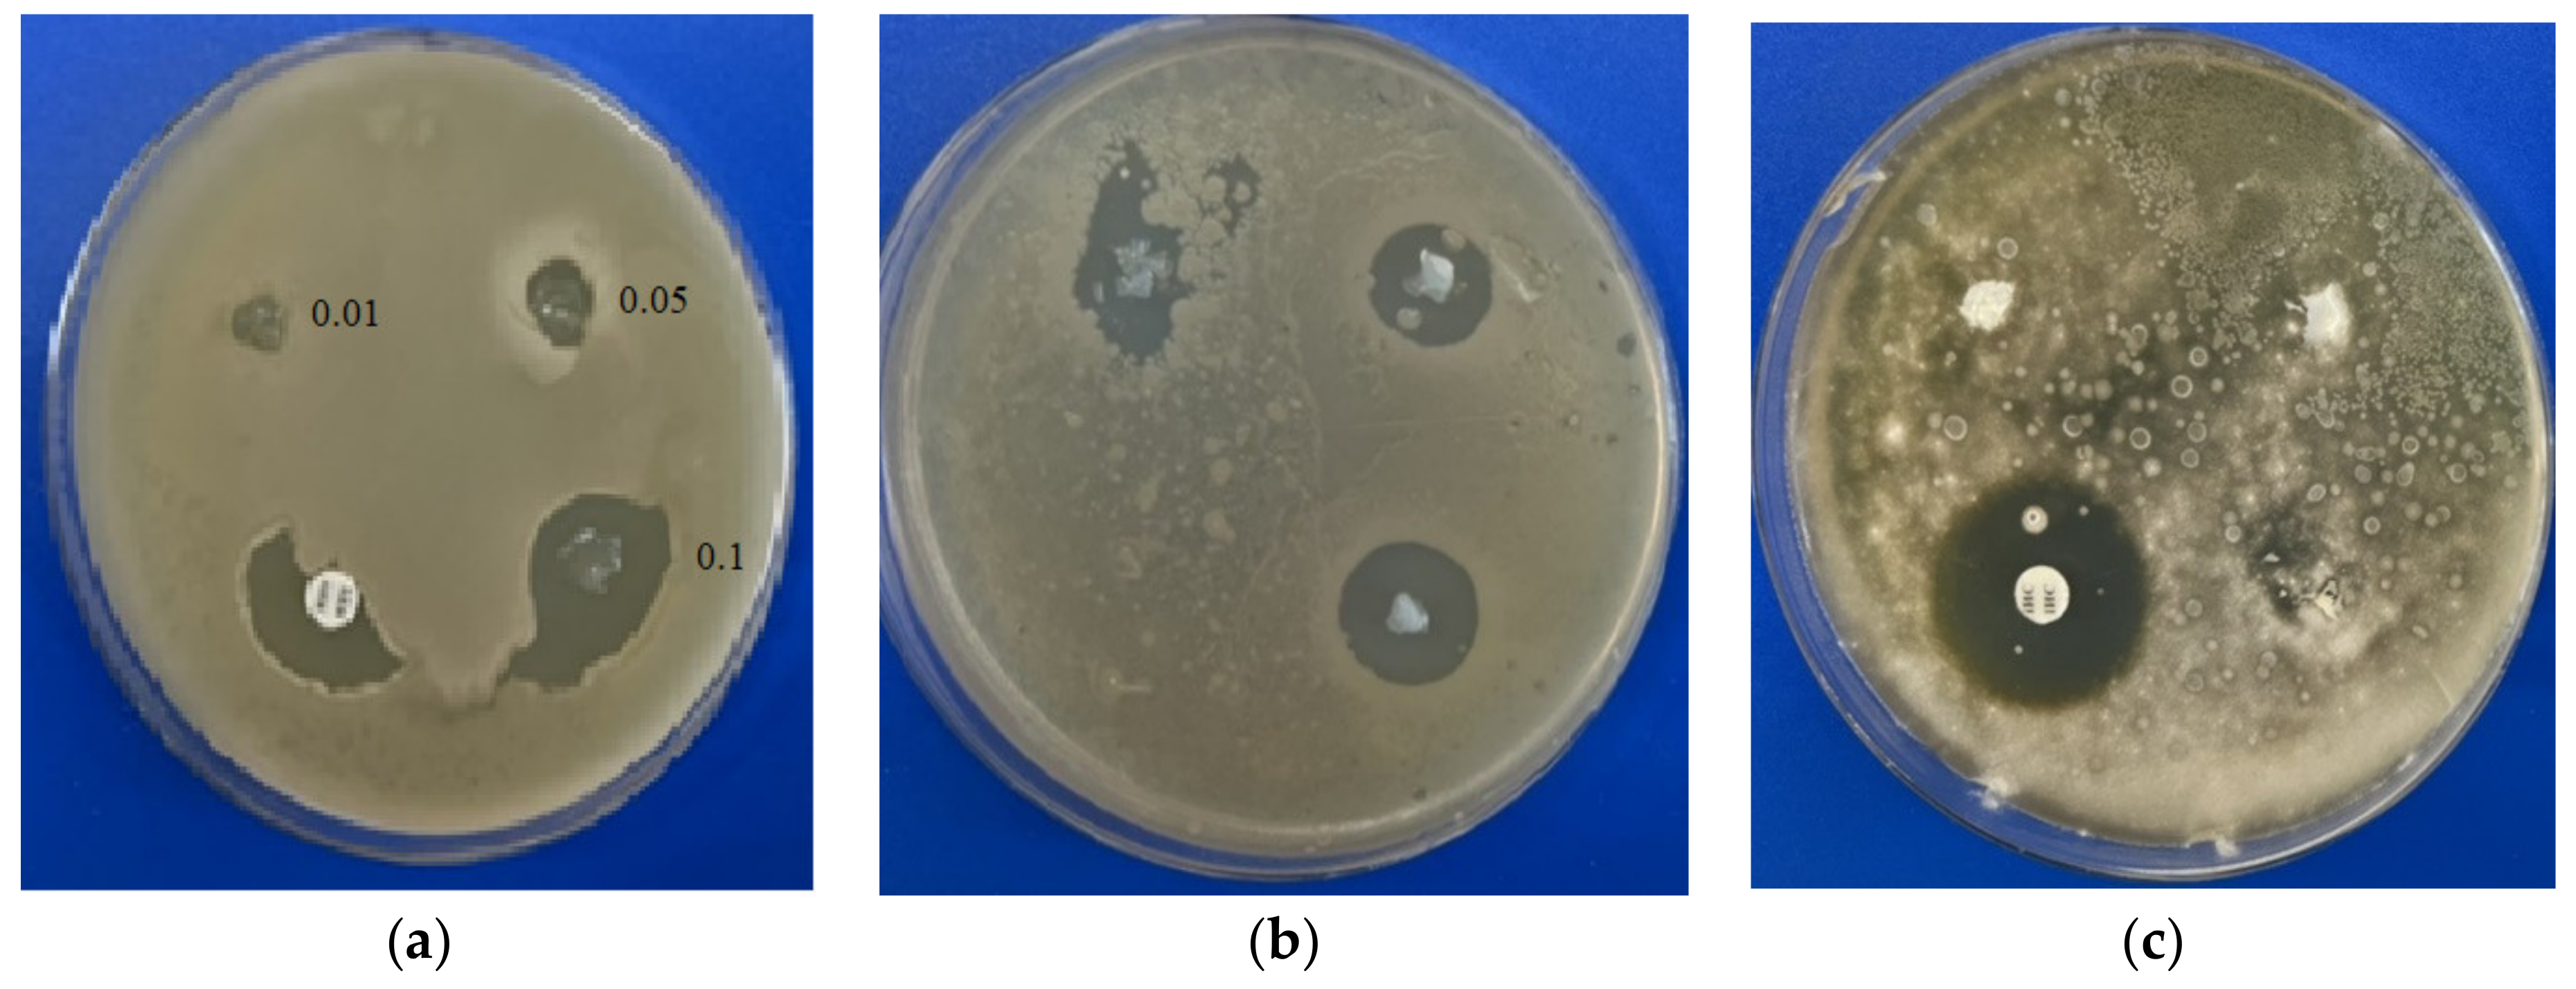
Ijms 23 04394 g004 550

Antiseptic Materials on the Base of Polymer Interpenetrating Networks Microgels and Benzalkonium Chloride
Abstract
:1. Introduction
2. Results and Discussion
2.1. The Interaction between IPN Microgels and Surfactant
2.2. IPN Microgel Macromaterials with BAKCl
2.3. Antimicrobial Properties of IPN Microgel Materials
3. Experimental Section
3.1. Materials
3.2. Microgel Synthesis
3.3. Microgel Macromaterials Preparation
3.4. Introduction of BAKCl
- (1)
- BAKCl species was added to the 0.2 wt.% aqueous solutions of PNIPAAm-PAA IPN microgels to acquire the surfactant concentration of 0.01 g/mL. The mixtures were left for 48 h, and then the microgel dispersion was purified from the unabsorbed BAKCl by several cycles of dialysis against water (dialysis bag pore size ~20,000 kDa). For antibacterial activity analysis, different concentrations of BAKCl-IPN aqueous solutions were prepared by diluting stock solutions.
- (2)
- The samples of PNIPAAm-PAA IPN material were placed in an aqueous solution of BAKCl, where they were kept for 7 days at room temperature. Then, the samples were washed several times in pure water to remove the excess BAKCl substance. To study the antibacterial properties, films with different ratios of absorbed surfactant to the mass of the substance were prepared. For this, the samples of material about the same weight were placed in water solutions with a different concentration of BAKCl.
3.5. Dynamic Light Scattering
3.6. Zeta Potential Measurements
3.7. UV-Spectrophotometry
3.8. Antimicrobial Activity Testing
4. Conclusions
Supplementary Materials
Author Contributions
Funding
Institutional Review Board Statement
Data Availability Statement
Acknowledgments
Conflicts of Interest
References
- Pich, A.; Richtering, W. Polymer Nanogels and Microgels. Polym. Sci. A Compr. Ref. 2012, 6, 309–350. [Google Scholar] [CrossRef]
- Preman, N.K.; Jain, S.; Johnson, R.P. “Smart” Polymer Nanogels as Pharmaceutical Carriers: A Versatile Platform for Programmed Delivery and Diagnostics. ACS Omega 2021, 6, 5075–5090. [Google Scholar] [CrossRef] [PubMed]
- Oh, J.K.; Drumright, R.; Siegwart, D.J.; Matyjaszewski, K. The development of microgels/nanogels for drug delivery applications. Prog. Polym. Sci. 2008, 33, 448–477. [Google Scholar] [CrossRef]
- Farooqi, Z.H.; Khan, S.R.; Begum, R. Temperature-responsive hybrid microgels for catalytic applications: A review. Mater. Sci. Technol. 2016, 33, 129–137. [Google Scholar] [CrossRef]
- Karg, M.; Pich, A.; Hellweg, T.; Hoare, T.; Lyon, L.A.; Crassous, J.J.; Suzuki, D.; Gumerov, R.A.; Schneider, S.; Potemkin, I.I.; et al. Nanogels and Microgels: From Model Colloids to Applications, Recent Developments, and Future Trends. Langmuir 2019, 35, 6231–6255. [Google Scholar] [CrossRef]
- Xia, X.; Hu, Z. Synthesis and Light Scattering Study of Microgels with Interpenetrating Polymer Networks. Langmuir 2004, 20, 2094–2098. [Google Scholar] [CrossRef]
- Kozhunova, E.Y.; Vyshivannaya, O.; Nasimova, I.R. “Smart” IPN microgels with different network structures: Self-crosslinked vs conventionally crosslinked. Polymer 2019, 176, 127–134. [Google Scholar] [CrossRef]
- Nigro, V.; Angelini, R.; Bertoldo, M.; Bruni, F.; Ricci, M.A.; Ruzicka, B. Dynamical behavior of microgels of interpenetrated polymer networks. Soft Matter 2017, 13, 5185–5193. [Google Scholar] [CrossRef]
- Nigro, V.; Angelini, R.; Rosi, B.; Bertoldo, M.; Buratti, E.; Casciardi, S.; Sennato, S.; Ruzicka, B. Study of network composition in interpenetrating polymer networks of poly(N isopropylacrylamide) microgels: The role of poly(acrylic acid). J. Colloid Interface Sci. 2019, 545, 210–219. [Google Scholar] [CrossRef] [Green Version]
- Nigro, V.; Angelini, R.; Bertoldo, M.; Buratti, E.; Franco, S.; Ruzicka, B. Chemical-Physical Behaviour of Microgels Made of Interpenetrating Polymer Networks of PNIPAM and Poly(acrylic Acid). Polymers 2021, 13, 1353. [Google Scholar] [CrossRef]
- Grinberg, V.Y.; Burova, T.V.; Grinberg, N.V.; Buyanovskaya, A.G.; Khokhlov, A.R.; Kozhunova, E.Y.; Vyshivannaya, O.V.; Nasimova, I.R. Functionalized thermoresponsive microgels based on N-isopropylacrylamide: Energetics and mechanism of phase transitions. Eur. Polym. J. 2020, 133, 109722. [Google Scholar] [CrossRef]
- Falk, N.A. Surfactants as Antimicrobials: A Brief Overview of Microbial Interfacial Chemistry and Surfactant Antimicrobial Activity. J. Surfactants Deterg. 2019, 22, 1119–1127. [Google Scholar] [CrossRef]
- Krasowska, A.; Biegalska, M.; Łukaszewicz, M. Comparison of antimicrobial activity of three commercially used quaternary ammonium surfactants. Sepsis 2012, 5, 170–174. [Google Scholar] [CrossRef]
- Vieira, D.B.; Carmona-Ribeiro, A.M. Cationic lipids and surfactants as antifungal agents: Mode of action. J. Antimicrob. Chemother. 2006, 58, 760–767. [Google Scholar] [CrossRef]
- McDonnell, G.E. Antisepsis, Disinfection, and Sterilization: Types, Action, and Resistance; ASM Press: Washington, DC, USA, 2007. [Google Scholar]
- Dolezal, R.; Soukup, O.; Malinak, D.; Savedra, R.; Marek, J.; Dolezalova, M.; Pasdiorova, M.; Salajkova, S.; Korabecny, J.; Honegr, J.; et al. Towards understanding the mechanism of action of antibacterial N-alkyl-3-hydroxypyridinium salts: Biological activities, molecular modeling and QSAR studies. Eur. J. Med. Chem. 2016, 121, 699–711. [Google Scholar] [CrossRef]
- Merchel Piovesan Pereira, B.; Tagkopoulos, I. Benzalkonium Chlorides: Uses, Regulatory Status, and Microbial Resistance. Appl. Environ. Microbiol. 2019, 85, e00377-19. [Google Scholar] [CrossRef] [Green Version]
- Gîfu, I.C.; Maxim, M.E.; Cinteza, L.O.; Popa, M.; Aricov, L.; Leontieș, A.R.; Anastasescu, M.; Anghel, D.-F.; Ianchis, R.; Ninciuleanu, C.M.; et al. Antimicrobial Activities of Hydrophobically Modified Poly(Acrylate) Films and Their Complexes with Different Chain Length Cationic Surfactants. Coatings 2019, 9, 244. [Google Scholar] [CrossRef] [Green Version]
- Solovskiy, M.V.; Panarin, E.F.; Kochetkova, I.S.; Anufrieva, E.V.; Pautov, V.D.; Afinogenov, G.E.; Koptova, T.V.; Ivantsova, T.M.; Vision, V.N. Makar’in A.S. Antiseptic Agent. Patent RF No. 1517173, 1986. [Google Scholar]
- Panarin, E.F.; Kopeikin, V.V. Biological activity of synthetic polyelectrolyte complexes of ionogenic surfactants. Polym. Sci. Ser. C 2002, 44, 185–194. [Google Scholar]
- Gentili, V.; Pazzi, D.; Rizzo, S.; Schiuma, G.; Marchini, E.; Papadia, S.; Sartorel, A.; Di Luca, D.; Caccuri, F.; Bignozzi, C.A.; et al. Transparent Polymeric Formulations Effective against SARS-CoV-2 Infection. ACS Appl. Mater. Interfaces 2021, 13, 54648–54655. [Google Scholar] [CrossRef]
- Tsao, N.; Kanakamma, P.P.; Luh, T.-Y.; Chou, C.-K.; Lei, H.-Y. Inhibition of Escherichia coli -Induced Meningitis by Carboxyfullerence. Antimicrob. Agents Chemother. 1999, 43, 2273–2277. [Google Scholar] [CrossRef] [Green Version]
- Zhou, C.; Wang, F.; Chen, H.; Li, M.; Qiao, F.; Liu, Z.; Hou, Y.; Wu, C.; Fan, Y.; Liu, L.; et al. Selective Antimicrobial Activities and Action Mechanism of Micelles Self-Assembled by Cationic Oligomeric Surfactants. ACS Appl. Mater. Interfaces 2016, 8, 4242–4249. [Google Scholar] [CrossRef] [PubMed]
- Bruna, T.; Maldonado-Bravo, F.; Jara, P.; Caro, N. Silver Nanoparticles and Their Antibacterial Applications. Int. J. Mol. Sci. 2021, 22, 7202. [Google Scholar] [CrossRef] [PubMed]
- Xue, H.; Zhao, Z.; Chen, S.; Du, H.; Chen, R.; Brash, J.L.; Chen, H. Antibacterial coatings based on microgels containing quaternary ammonium ions: Modification with polymeric sugars for improved cytocompatibility. Colloids Interface Sci. Commun. 2020, 37, 100268. [Google Scholar] [CrossRef]
- Sharma, B.; Clem, C.M.; Perez, A.D.; Striegler, S. Antimicrobial Activity of Microgels with an Immobilized Copper(II) Complex Linked to Cross-Linking and Composition. ACS Appl. Bio Mater. 2020, 3, 7611–7619. [Google Scholar] [CrossRef]
- Häntzschel, N.; Hund, R.-D.; Hund, H.; Schrinner, M.; Lück, C.; Pich, A. Hybrid Microgels with Antibacterial Properties. Macromol. Biosci. 2009, 9, 444–449. [Google Scholar] [CrossRef] [PubMed]
- Nasimova, I.R.; Vyshivannaya, O.V.; Gallyamov, M.O.; Kozhunova, E.Y. Thermo- and pH-Sensitive Microgels Based on Interpenetrating Networks as Components for Creating Polymeric Materials. Polym. Sci. Ser. A 2019, 61, 773–779. [Google Scholar] [CrossRef]
- Nasimova, I.; Rudyak, V.; Doroganov, A.; Kharitonova, E.; Kozhunova, E. Microstructured Macromaterials Based on IPN Microgels. Polymers 2021, 13, 1078. [Google Scholar] [CrossRef]
- Philippova, A.R. Khokhlov, Polyelectrolyte/Ionomer Behavior of Polymer Gels. In Polymer Gels and Networks, 1st ed.; Osada, Y., Khokhlov, A., Eds.; CRC Press: Boca Raton, FL, USA, 2001; pp. 170–183. [Google Scholar] [CrossRef]
- Kleinen, J.; Richtering, W. Polyelectrolyte microgels based on poly-N-isopropylacrylamide: Influence of charge density on microgel properties, binding of poly-diallyldimethylammonium chloride, and properties of polyelectrolyte complexes. Colloid Polym. Sci. 2011, 289, 739–749. [Google Scholar] [CrossRef]
- Richter, M.; Zakrevskyy, Y.; Eisele, M.; Lomadze, N.; Santer, S.; Klitzing, R.V. Effect of pH, co-monomer content, and surfactant structure on the swelling behavior of microgel-azobenzene-containing surfactant complex. Polymer 2014, 55, 6513–6518. [Google Scholar] [CrossRef]
- Bradley, M.; Liu, D.; Keddie, J.L.; Vincent, B.; Burnett, G. The Uptake and Release of Cationic Surfactant from polyampholyte Microgel Particles in Dispersion and as an Adsorbed Monolayer. Langmuir 2009, 25, 9677–9683. [Google Scholar] [CrossRef]
- Bradley, M.; Vincent, B. Poly(vinylpyridine) Core/Poly(N-isopropylacrylamide) Shell Microgel Particles: Their Characterization and the Uptake and Release of an Anionic Surfactant. Langmuir 2008, 24, 2421–2425. [Google Scholar] [CrossRef]
- Kozhunova, E.Y.; Rudyak, V.Y.; Li, X.; Shibayama, M.; Peters, G.S.; Vyshivannaya, O.V.; Nasimova, I.R.; Chertovich, A.V. Microphase separation of stimuli-responsive interpenetrating network microgels investigated by scattering methods. J. Colloid Interface Sci. 2021, 597, 297–305. [Google Scholar] [CrossRef]
- NCCLS. NCCLS Reference Method for Broth Dilution Antibacterial Susceptibility Testing; Clinical and Laboratory Standards Institute: Pittsburgh, PA, USA, 2000; p. 22. [Google Scholar]
- CLSI M38-A2; Reference Method for Broth Dilution Antifungal Susceptibility Testing of Filamentous Fungi. 2nd ed. Approved Standart. Clinical and Laboratory Standards Institute: Pittsburgh, PA, USA, 2008.
- CLSI M27-S3; Reference Method for Broth Dilution Antifungal Susceptibility Testing of Yeasts. Clinical and Laboratory Standards Institute: Pittsburgh, PA, USA, 2013.
- Pigaleva, M.A.; Novikov, I.V.; Nikolaev, A.Y.; Vasil’Ev, V.G.; Abramchuk, S.S.; Naumkin, A.V.; Arkharova, N.A.; Sadykova, V.S.; Kuvarina, A.E.; Gallyamov, M.O. Platinum cross-linked chitosan hydrogels synthesized in water saturated with CO2 under high pressure. J. Appl. Polym. Sci. 2020, 138, 50006. [Google Scholar] [CrossRef]
- Pich, A.; Richtering, W. Microgels by Precipitation Polymerization: Synthesis, Characterization, and Functionalization. In Radical Polymerisation Polyelectrolytes; Springer Science and Business Media LLC: Berlin/Heidelberg, Germany, 2010; Volume 234, pp. 1–37. [Google Scholar]
- Benzalkonium Chloride. Available online: www.sigmaaldrich.com/RU/en/product/sial/12060 (accessed on 20 March 2022).
- Benzalkonium Chloride. Available online: https://www.chembk.com/en/chem/8001-54-5 (accessed on 20 March 2022).
- Iselt, M.; Holtei, W.; Hilgard, P. The tetrazolium dye assay for rapid in vitro assessment of cytotoxicity. Arzneimittelforschung 1989, 39, 747–749. [Google Scholar]

| Test Strains | BAKCl/IPN mg/L | IPN Control | Amoxiclav/Clavulonic Acid 20/10 mg/L | Amphotericin B 40 mg/L |
|---|---|---|---|---|
| Staphylococcus aureus ATCC 25923 | 0.4 | - | 0.25 | * |
| Bacillus subtilis ATCC 6633 | 0.02 | - | 0.01 | * |
| Aspergillus niger ATCC 16404 | 2 | - | * | 1 |
| Compounds | Zone of Inhibition, mm, g BAKCl/g Film | |||||
|---|---|---|---|---|---|---|
| Test Strains | 0.1 | 0.05 | 0.01 | 0.002 | Amoxiclav/Clavulonic Acid 20/10 µg | Amphotericin B 40 µg |
| Staphylococcus aureus ATCC 25923 | 18 | 14 | 10 | 7 | 15 | - |
| Bacillus subtilis ATCC 6633 | 25 | 15 | 13 | 11 | >35 | - |
| Aspergillus niger ATCC 16404 | 20 | 0 | 0 | 0 | * | 14 |
Publisher’s Note: MDPI stays neutral with regard to jurisdictional claims in published maps and institutional affiliations. |
© 2022 by the authors. Licensee MDPI, Basel, Switzerland. This article is an open access article distributed under the terms and conditions of the Creative Commons Attribution (CC BY) license (https://creativecommons.org/licenses/by/4.0/).
Share and Cite
Kozhunova, E.Y.; Komarova, G.A.; Vyshivannaya, O.V.; Nasimova, I.R.; Kuvarina, A.E.; Sadykova, V.S. Antiseptic Materials on the Base of Polymer Interpenetrating Networks Microgels and Benzalkonium Chloride. Int. J. Mol. Sci. 2022, 23, 4394. https://doi.org/10.3390/ijms23084394
Kozhunova EY, Komarova GA, Vyshivannaya OV, Nasimova IR, Kuvarina AE, Sadykova VS. Antiseptic Materials on the Base of Polymer Interpenetrating Networks Microgels and Benzalkonium Chloride. International Journal of Molecular Sciences. 2022; 23(8):4394. https://doi.org/10.3390/ijms23084394
Chicago/Turabian StyleKozhunova, Elena Yu., Galina A. Komarova, Oxana V. Vyshivannaya, Irina R. Nasimova, Anastasia E. Kuvarina, and Vera S. Sadykova. 2022. "Antiseptic Materials on the Base of Polymer Interpenetrating Networks Microgels and Benzalkonium Chloride" International Journal of Molecular Sciences 23, no. 8: 4394. https://doi.org/10.3390/ijms23084394
APA StyleKozhunova, E. Y., Komarova, G. A., Vyshivannaya, O. V., Nasimova, I. R., Kuvarina, A. E., & Sadykova, V. S. (2022). Antiseptic Materials on the Base of Polymer Interpenetrating Networks Microgels and Benzalkonium Chloride. International Journal of Molecular Sciences, 23(8), 4394. https://doi.org/10.3390/ijms23084394

